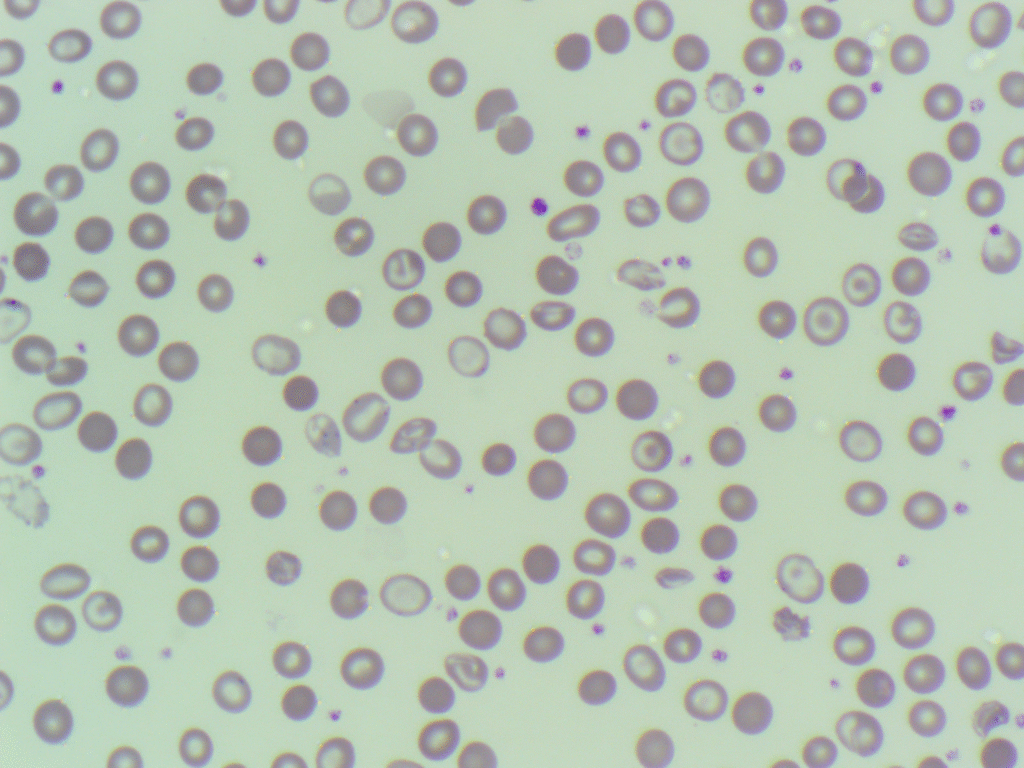
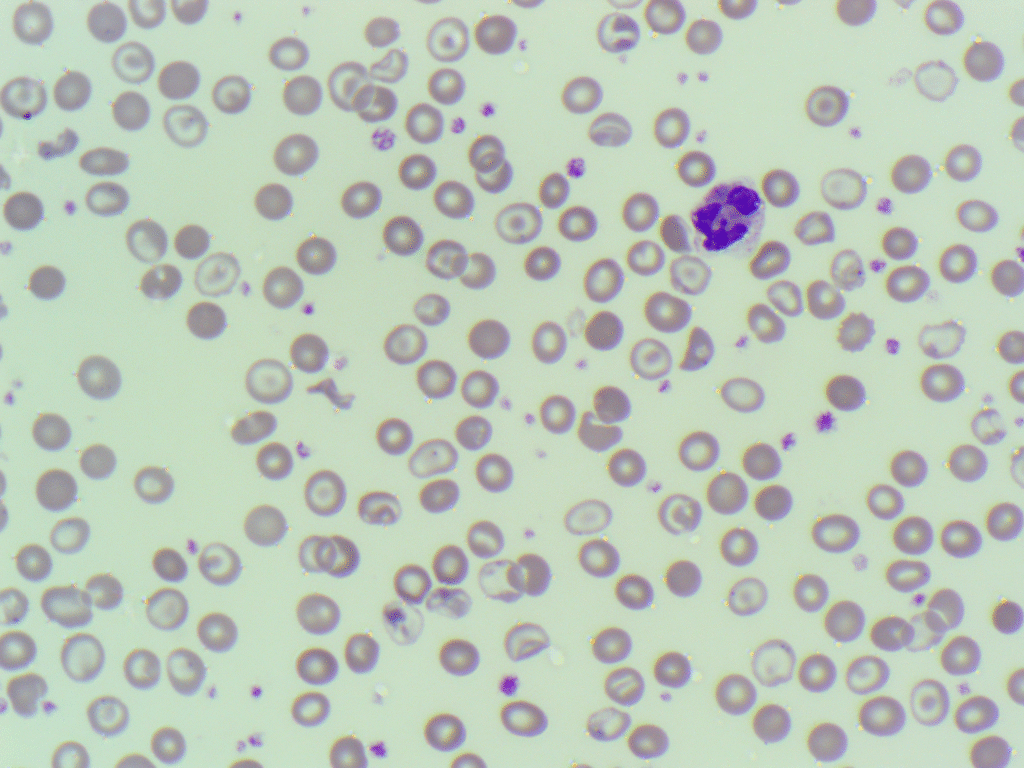

This week’s Morphology Monday case featured a 60-year-old female whose full blood count prompted further investigation:
Full blood count results:
- WBC: 11.58 ×10⁹/L
- RBC: 3.16 ×10¹²/L
- Hb: 84 g/L
- HCT: 0.256
- MCV: 81 fL
- MCHC: 328 g/L
- RDW: 22.5%
- PLT: 669 ×10⁹/L
A blood film review was requested following a low haemoglobin level and markedly raised platelet count. The film revealed a dimorphic red cell population, with both normocytic-normochromic and hypochromic cells present. Numerous target cells, occasional Howell-Jolly bodies, and basophilic stippling were also noted.

These findings raised the possibility of a haemoglobinopathy. Given the red cell morphology and raised RDW, follow-up testing was advised.
Key learning points:
- A dimorphic red cell picture with target cells and stippling should raise suspicion for haemoglobinopathies.
- Howell-Jolly bodies may point to functional hyposplenism or splenic absence, warranting further clinical correlation.
- Thalassaemia can present with a normal MCV if there’s co-existing normocytic cell production.